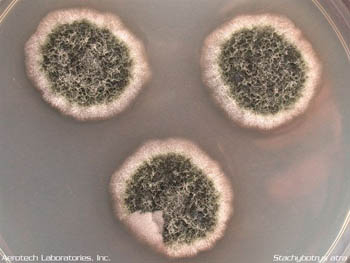
What Toxic Black Mold In A Petri Dish Home Mold Test Kit Looks Like? for Black Mold In Petri Dish

Picture this: a tiny speck of black mold, barely visible to the naked eye, placed in a petri dish filled with nutrient-rich agar. What unfolds next is a fascinating tale of biological adaptation, exponential growth, and the remarkable resilience of fungi. This isn't just about mold getting bigger - it's about understanding how nature's most persistent organisms thrive in controlled environments.
Black mold, scientifically known as Stachybotrys chartarum, might seem like just another household annoyance. But when researchers place this organism in the controlled environment of a petri dish, something extraordinary happens. The mold doesn't just survive - it transforms. It becomes a living textbook of biological processes, revealing secrets about how fungi adapt to their surroundings. These little experiments in laboratory settings have given us profound insights into everything from medical treatments to environmental remediation. The story begins with a simple question: what happens when we let black mold loose in a petri dish?
The Laboratory Playground
When black mold is introduced to a petri dish, it immediately begins its transformation. The agar medium provides all the nutrients it needs - sugars, proteins, and minerals. Within hours, you'll see the first signs of growth. Spores begin to germinate, sending out tiny threads called hyphae that spread outward like roots. These aren't just random movements. They follow specific patterns, responding to chemical gradients and physical cues in their environment.
The process starts slow, almost imperceptibly. But within 24 to 48 hours, the colony becomes visible to the naked eye. What's particularly interesting is how quickly the mold adapts to its new home. It doesn't simply grow in one direction. Instead, it creates a complex network of filaments that branch and weave together, forming a three-dimensional structure.
This growth pattern isn't just beautiful to observe - it's scientifically significant. Researchers can actually map how the mold responds to different variables, such as temperature, humidity, and pH levels. The petri dish becomes a miniature ecosystem where every change affects the outcome.
Nutrient Competition and Survival Tactics
In the confined space of a petri dish, resources become precious commodities. Black mold must compete with itself and potentially other microorganisms for limited nutrients. This competition drives some fascinating behaviors.
The mold doesn't just absorb nutrients passively. It actively seeks them out, creating specialized structures that maximize efficiency. These structures can actually change shape based on nutrient availability. When food is abundant, the mold grows rapidly in all directions. When resources become scarce, it forms compact, dense colonies that conserve energy.
One particularly striking behavior occurs when multiple colonies meet. Instead of simply growing over each other, they engage in what scientists call "antagonistic interactions." Some molds produce chemicals that inhibit nearby competitors. Others develop resistance mechanisms to survive in hostile environments.
These behaviors mirror what happens in nature, but on a much smaller scale. It's like watching evolution happen in real time, except instead of millions of years, we see it unfold in days or weeks.
Environmental Response and Adaptation
The petri dish environment can be precisely controlled, allowing scientists to test how black mold reacts to various conditions. Temperature changes alone can dramatically alter growth patterns. At cooler temperatures, growth slows significantly. Warmer conditions often accelerate development, but too much heat can cause stress responses.
Humidity plays an equally important role. In high-humidity conditions, the mold produces more spores and grows faster. Low humidity, however, forces the organism to enter a dormant state, conserving energy until conditions improve.
pH levels also matter enormously. Black mold prefers slightly acidic conditions, typically around 5.0 to 6.0. When the environment becomes too alkaline, the mold's growth rate drops sharply. This sensitivity to environmental factors makes it an excellent indicator species for monitoring air quality and contamination levels.
What's amazing is how quickly these adaptations occur. Scientists have observed that even small changes in environmental conditions can trigger dramatic shifts in growth patterns within just a few days.
Spore Production and Dispersal Patterns
One of the most captivating aspects of black mold in petri dishes is its spore production. These microscopic reproductive units are the mold's way of ensuring survival and expansion.
Under optimal conditions, a single mold colony can produce thousands of spores within a matter of days. These spores are incredibly resilient, capable of surviving harsh conditions until they find suitable environments.
The distribution of these spores follows predictable patterns. They tend to cluster around areas of high nutrient concentration and favorable moisture levels. When environmental conditions become unfavorable, spore production increases dramatically.
Researchers have discovered that the timing of spore release is crucial for survival. Too early, and the spores may not find suitable locations. Too late, and the parent colony may die before dispersal occurs. This delicate balance represents millions of years of evolutionary refinement.
Understanding these patterns helps explain why black mold can be so difficult to eliminate once established in buildings. The spores can remain dormant for extended periods, waiting for the right moment to reawaken.
Mold Colonies and Community Dynamics
A petri dish isn't just a single mold colony - it's a complex community of organisms interacting with each other. Sometimes, black mold grows alongside other fungi or bacteria, creating intricate relationships.
In some cases, different organisms form mutualistic partnerships. One might provide nutrients while another offers protection. These relationships can enhance growth rates and overall survival.
Other times, the interactions are more competitive. Different species of fungi may fight over the same resources, leading to complex chemical warfare. Some produce antibiotics that kill competitors while others develop resistance mechanisms.
The colony structure itself reveals a lot about how these organisms organize themselves. Rather than growing randomly, the mold forms distinct zones with different characteristics. Nutrient-rich areas support rapid growth, while nutrient-poor regions become more sparse and compact.
These patterns aren't just academic curiosities. They help us understand how mold communities develop in real-world environments, from old buildings to agricultural settings.
Practical Applications and Real-World Implications
The research conducted in petri dishes has far-reaching implications beyond the laboratory. Understanding how black mold grows and spreads helps us develop better methods for preventing contamination in various industries.
In healthcare, knowing how mold responds to different conditions helps prevent infections in hospitals and clinics. The same knowledge applies to food processing facilities, where mold contamination can ruin entire batches of products.
Archaeological sites benefit from this research too. Scientists use similar techniques to understand how organic materials deteriorate over time, helping preserve historical artifacts.
Environmental scientists apply these findings to monitor air quality in urban areas. The presence of black mold spores in indoor environments can indicate poor ventilation or water damage problems.
Even in agriculture, the insights gained from petri dish studies help farmers prevent crop diseases. By understanding how fungi spread and reproduce, they can develop better prevention strategies.
The bottom line? Everything we learn in those small petri dishes translates into solutions for real-world problems.
What happens when black mold meets petri dish culture conditions isn't just a scientific curiosity - it's a window into the fundamental processes that govern life itself. From the moment the spores land on that nutrient-rich agar, to the formation of complex colonies, every step reveals something new about biological adaptation and survival. These tiny experiments have given us powerful tools for understanding larger ecological systems, improving public health, and protecting our built environment.
The next time you encounter black mold in your home or workplace, remember that what you're seeing is just the tip of the iceberg. Beneath the surface lies a complex world of interactions, adaptations, and survival strategies that scientists are still learning to decode. Whether it's a simple laboratory experiment or a complex ecosystem, the principles remain the same. Nature finds a way to thrive, even in the most controlled conditions. The story of black mold in petri dishes continues to unfold, offering new insights every day.